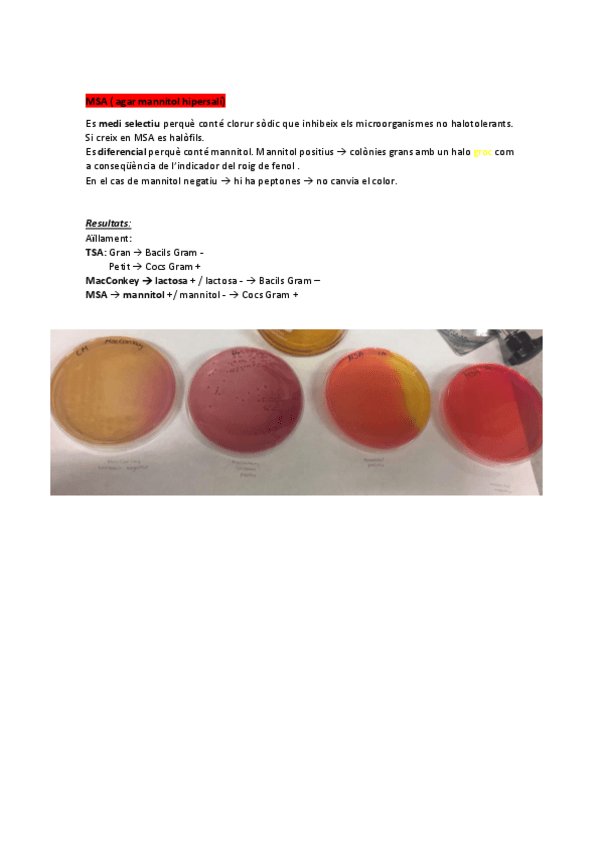

@sunsunasun
16 Publicaciones
1.09k Interacciones
0 Seguidores
0 Siguiendo
Lista de publicaciones de sunsunasun
He publicado nuevos apuntes de 4º Salud Pública: resum-seminari-epidemiologia-analitica-2.pdf
He publicado nuevos apuntes de 4º Salud Pública: resum-seminari-epidemologia-analitica-1.pdf
He publicado nuevos apuntes de 4º Salud Pública: seminari-epidemologia-2-.pdf
He publicado nuevos apuntes de 4º Salud Pública: seminari-epidemologia-1.pdf
He publicado nuevos apuntes de 3º Microbiología II: annex-micro-deespres-del-parcial-.pdf
He publicado nuevos apuntes de 4º Farmacologia I Terapèutica I: esquema-farmacs-antifungics-.pdf
He publicado nuevos examenes de 4º Ingeniería Genética: questionari-online-2.pdf
He publicado nuevos apuntes de 3º Microbiología II: index-2n-parcial-.pdf
He publicado nuevos apuntes de 3º Microbiología II: resum-de-practiques-amb-fotos.pdf
He publicado nuevos apuntes de 3º Microbiología II: resum-de-practiques-amb-fotos.pdf
He publicado nuevos apuntes de 3º Microbiología II: preguntes-de-examen.pdf
He publicado nuevos apuntes de 4º Farmacognosia: Questionari-ERI-FG-4-.pdf
He publicado nuevos apuntes de 4º Farmacognosia: Questionari-ERI-FG-3.pdf
He publicado nuevos apuntes de 4º Farmacognosia: Questionari-ERI-FG-2.pdf
He publicado nuevos apuntes de 4º Farmacognosia: Questionari-ERI-FG1.pdf
He publicado nuevos examenes de 4º Ingeniería Genética: Test-TED-TALKS.pdf